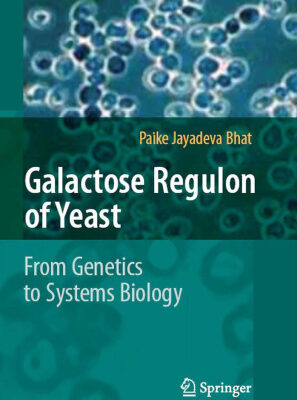

خرید و دانلود نسخه کامل کتاب Biopsy Pathology in Colorectal Disease, 2nd edition
74,500 تومان قیمت اصلی 74,500 تومان بود.37,000 تومانقیمت فعلی 37,000 تومان است.
تعداد فروش: 44
| عنوان فارسی | پاتولوژی بیوپسی در بیماری کولورکتال، ویرایش دوم |
|---|---|
| عنوان اصلی | Biopsy Pathology in Colorectal Disease, 2nd edition |
| ویرایش | 2 |
| ناشر | |
| نویسنده | Ian Talbot, Ashley Price, Manuel Salto-Tellez |
| ISBN | 0340759224, 9780340759226 |
| سال نشر | 2007 |
| زبان | English |
| تعداد صفحات | 422 |
| دسته | بیوفیزیک |
| فرمت کتاب | pdf – قابل تبدیل به سایر فرمت ها |
| حجم فایل | 45 مگابایت |
آنتونی رابینز میگه : من در 40 سالگی به جایی رسیدم که برای رسیدن بهش 82 سال زمان لازمه و این رو مدیون کتاب خواندن زیاد هستم.
توضیحاتی در مورد کتاب
آسیب شناسی بیوپسی در بیماری کولورکتال نشان می دهد که چگونه پاتولوژیست شاغل می تواند حداکثر ارزش تشخیصی را از بیوپسی کولون، رکتوم و مقعد استخراج کند. با پیشرفت در تکنیکهای بیوپسی مخاط کولونوسکوپی، این نمونهها از جمله نمونههایی هستند که اغلب در بخشهای هیستوپاتولوژی بیمارستان با آن مواجه میشوند. این نسخه جدید به پاتولوژیستهای شاغل و آنهایی که در رشتههای وابسته هستند، راهنمای کاملی برای تشخیص بیماریهای کولورکتال، معمولی و نادر، ارائه میدهد و راهنماییهای متخصص را در رسیدگی به نمونههای بیوپسی ارائه میدهد. با ارزش ترین اطلاعات برای تفسیر تشخیصی انواع مختلف بیماری های التهابی به طور واضح و مختصر ارائه شده است و استفاده از اصطلاحات غیر تشخیصی مانند کولیت غیر اختصاصی را به حداقل می رساند. روش های بهینه رسیدگی و بررسی پولیپ ها، ارزیابی بیوپسی در اختلالات حرکتی و تفسیر بیوپسی ضایعات مقعدی شرح داده شده است. یک طبقه بندی منطقی و رویکرد عملی به دیسپلازی ارائه شده است. فصلهای اولیه چگونگی تشخیص بسیاری از ویژگیهای مختلف، چه طبیعی و چه غیرطبیعی را شرح میدهند که میتوان آنها را به عنوان نشانههای تشخیص در نظر گرفت. اهمیت این علائم تشخیصی به طور خلاصه شرح داده شده و به فصلهای بعدی که در آن ویژگیهای بافتشناسی موارد خاص است ارجاع داده شده است. بیماری ها در عمق بیشتری پوشش داده می شوند.



نقد و بررسیها
هنوز بررسیای ثبت نشده است.